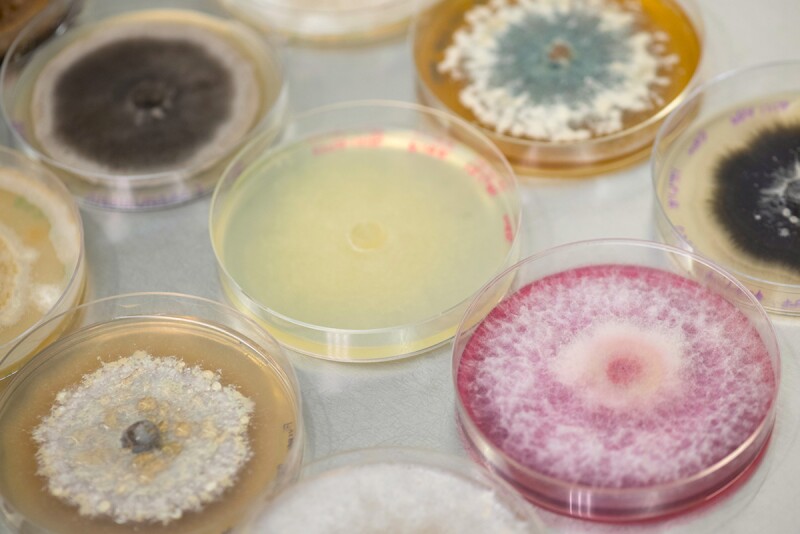
Petri Dishes.jpg

Long before soil biology and microbial inoculants became paramount for produce growers and agtech companies alike, Linda Kinkel was digging — literally and figuratively — into the relationships between microbes and plants. As a young faculty member at the University of Minnesota nearly 35 years ago, she encountered a field where something unusual was happening: after 30 years of monoculture potato cropping, the soil had become virtually immune to disease.
“No grower would grow potatoes every year in the same field for 30 years,” Kinkel says, “but this was a breeding nursery for the fresh market potato industry. It was a great spot to have lots of disease pressure, but after 30 years, there was no disease. You could put pathogens in that soil and there was no infection.”
The discovery sparked what became a lifelong career of research into soil microbes and their capacity to build disease resistance, improve nutrient uptake and enhance overall crop productivity.
“I spent more years than I care to admit trying to find the microbe responsible,” she says. “What became clear was that there was no one microbe. It was partnerships, microbes interacting. And specifically, the way they interacted led to this amazing disease suppression, so — partners matter.”
That principle, partners matter, has guided her scientific journey ever since. It also played a key role in her being named a Top Agri-Food Pioneer by the World Food Prize Foundation in 2025.
From science to solutions
Kinkel co-founded Jord BioScience to make microbial products that are not only effective but also consistent, something the biologicals industry has long struggled with, Kinkel says.
“Growers need consistent tools,” she says. “That’s a huge opportunity, and one of the primary goals of Jord: to lift that consistency while seeking to outperform chemistries.
Though microbial technologies like bio-stimulants, bio-fertilizers and biopesticides aren’t new, their relevance to fresh produce and specialty crops is rapidly growing. And according to Kinkel, they’re far from a one-size-fits-all tool.
For the fresh produce industry, the potential is great, Kinkel says.
“These aren’t crop-specific technologies,” she says. “There’s no reason they can’t be adaptable to any crop, any mode of application, any grower objective. If a grower needs disease control of a particular pathogen in leafy greens, or enhanced phosphorus uptake in apples, or stronger biostimulant action in potatoes, we can optimize inoculants to those needs.”
At Jord BioScience, Kinkel says, the company is already working with leafy greens, and she, personally, has long experience in potato and apple production.
“Earlier in my career, I worked on inoculation of apples to protect the fruit,” she adds.
Special solutions for specialty crops
What excites Kinkel most about the future of microbial solutions is their potential in specialty crop systems, where diversity in crops and growing environments demands flexibility.
“Specialty crops offer a special opportunity,” she says. “There’s so much diversity — so many crops, challenges and habitats. That’s where biology shines. Chemistry usually has one active ingredient applied broadly, but that’s not how biology works. Microbes allow for bespoke solutions that can be tailored not just to the crop, but to the specific farm or region.”
And thanks to advances in fermentation technology, application method flexibility and inoculant stability, many previous barriers to microbial adoption are falling away.
“Our microbes are agnostic to application method,” Kinkel says. “Whether it’s foliar, soil or something else, we can work with it. Biologicals are becoming much more adaptable and stable.”
Still, one major challenge remains, particularly for produce: field validation.
“You must have that field validation to provide the rigor and confidence growers need,” she says. “The diversity in specialty crops makes it harder to build large-scale testing platforms. But it’s our responsibility in the biologicals industry to make those investments, to prioritize the right needs and bring real value to growers.”
A lifelong fan of the “good guys”
Kinkel’s fascination with soil microbes began during a college course in plant pathology that focused almost entirely on pathogens.
“There was one lecture, just one, on beneficial microbes,” she says. “And I thought, what the heck? Why don’t we know more about the good guys? That question really defined my career.”
“The soil is filled with an entire universe of microbes that are doing big jobs for us every day, thanklessly,” Kinkel says. “My passion has always been to understand the who, how and why of these microbial interactions, and how we can manage them for better outcomes in food security and agriculture.”
Even after more than three decades in the field, her enthusiasm hasn’t waned.
“I’m not young anymore,” Kinkel laughs, “but I still see such potential in what we can do with soil microbiology. It’s a great tool.”
Top Agri-Food Pioneer recognition
As she prepares to be honored by the World Food Prize Foundation this year alongside a new cohort of innovators, Kinkel reflects on her journey and the mentors who inspired her, including Norman Borlaug, whom she met early in her career at the University of Minnesota.
“It’s humbling to be part of Dr. Borlaug’s broad footprint, however small my piece may be,” she says. “I’m especially proud that our collaborative team at Jord is being recognized. Microbes work best in collaboration — and so do we.”
The second annual Top Agri-Food Pioneers includes 39 changemakers from 27 countries forging a new future for food, according to a news release by the World Food Prize Foundation. The honorees, including Kinkel, will be formally recognized during the 2025 Norman E. Borlaug International Dialogue, taking place Oct. 21–23 in Des Moines, Iowa.
“The 2025 TAP list showcases the extraordinary diversity, talent and resolve of individuals working across borders and disciplines to build a more sustainable and just global food system,” says Mashal Husain, president of World Food Prize Foundation. “In a world facing urgent and interwoven crises, these honorees are fearless changemakers driving impact where it matters most — and offering real hope for the future.”